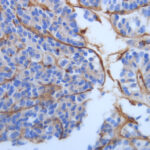

Anatomía Patológica en Clave Molecular: El Nuevo Rol del Patólogo en la Era Genómica.
La anatomía patológica es una de las especialidades más antiguas de la medicina y como [...]
Read More
28
Oct
Oct
Los Fibroblastos Tumorales: ¿Los Vecinos Indeseables del Microambiente Tumoral?
El término fibroblasto (FB) y su descripción detallada se atribuyen a Karl Langerhans en 1870. [...]
Read More
05
Apr
Apr